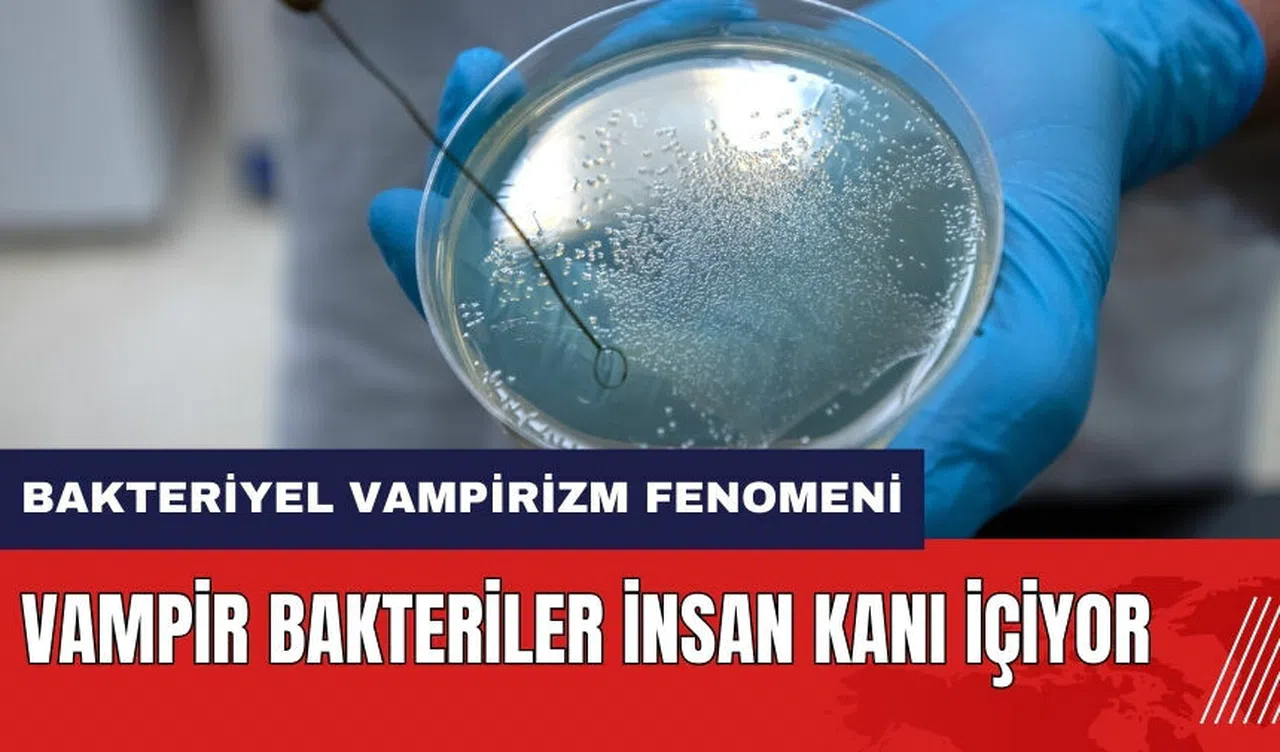

Washington Eyalet Üniversitesi'ndeki araştırmacılar, Salmonella ve E. coli gibi gıda kaynaklı hastalıklara neden olan bakteriler arasında 'bakteriyel vampirizm' olarak adlandırılan yeni bir fenomeni keşfettiler.
Bu mikroorganizmaların, insan vücudunda ölümcül hale geldiklerinde kan dolaşımını nasıl hedef aldıkları uzun zamandır bilinmiyordu. Ekip, bakterilerin, içerdikleri besinleri kan gibi sıvılara çekerek kan dolaşımına girmesini sağlayan bir özellik keşfetti.
Kan Zehirlenmesine Sebep Olan Bakteriyel Vampirizm
Patojenler, sindirim sistemindeki kesiklerden kolayca kan dolaşımına geçebilen sıvıların nerede olduğunu tespit edebiliyorlar.
Bu durum bazen bağırsak hastalığı olan kişilerde sepsis, yani kan zehirlenmesi nedeniyle ölüme sebep olabiliyor. Bir damla kan, vampir bakterileri kendisine çekiyor.

İnsan Kanına Yöneliyor
Araştırma ekibinin lideri Profesör Arden Baylink, durumu şöyle açıkladı: 'Kan dolaşımını enfekte eden bakteriler ölümcül olabilir. Bakterilerin, kan dolaşımındaki bir kimyasal maddeyi algılayıp doğru yöne yüzdüklerini öğrendik.'
E. coli ve Salmonella gibi bakteriler, insan kanındaki çok küçük miktarlardaki kimyasal maddeleri dahi algılayabilirler. Bu bakteriler, kanı bağırsaklara sızdıran kesikleri tespit ettiklerinde, kan dolaşımına girmek için harekete geçebilirler.
 Uzmanlar yatak çarşaflarındaki bakterilerin risklerini açıkladı!
Uzmanlar yatak çarşaflarındaki bakterilerin risklerini açıkladı!